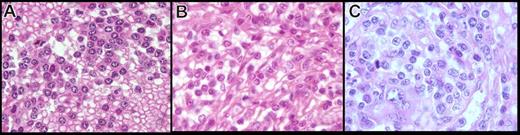
Figure 3. Spleen cytology in paraffin-embedded tissue of the present series (hematoxylin-eosin safran stain, original magnification ×100). The cells observed in the present series on spleen sections showed two distinctive features: (A) cells with round nucleus, clumped chromatin, and abundant basophilic cytoplasm, (B) cells with more irregular nucleus, less clumped chromatin, and less abundant cytoplasm, and (C) an increase in atypical cells with a prominent nucleolus, increase in large cells, and mitosis in morphologically transformed cases.

The presence of circulating villous lymphocytes (VLs) in lymphoma patients usually points to splenic marginal zone B-cell lymphoma (SMZL), even if the VLs can be found occasionally in other small B-cell lymphomas. However, those cells are variably described, and detailed cytologic characterization is often lacking. We identified lymphoma cases with numerous basophilic VLs among the large group of splenic lymphoma with VLs, and for further delineation, 37 cases with this particular cytology were analyzed. Patients, predominantly older men, presented with moderate lymphocytosis and splenomegaly without pancytopenia. The monoclonal B cells expressed IgM + D, IgM + G, IgM or IgG, as well as CD76 and CD11c, frequently CD103, and rarely CD123. Spleen sections were peculiar, with atrophic white pulp and a monomorphic diffuse lymphoma infiltration in a congested red pulp. Bone marrow infiltration was interstitial and intrasinusoidal without extensive fibrosis. Cytogenetic analysis showed a frequent absence of clonal aberrations (68%). Most cases (79%) were IgH mutated, with an overrepresentation of VH3 and VH4 gene families. These results, as well as the clinical evolution, show that those lymphoma cases represent a homogeneous group distinct from SMZL and reminiscent of hairy cell leukemia variant, perhaps corresponding to a separate lymphoma entity.
Introduction
Cells with cytoplasmic expansions in peripheral blood (PB) have been described in a variety of small B-cell lymphomas, including splenic marginal zone B-cell lymphoma/splenic lymphoma with villous lymphocytes (SMZL/SLVL), hairy cell leukemia (HCL), and hairy cell leukemia variant (HCL-V). Although SMZL and HCL are well-described entities, the definitions of SLVL and HCL-V remain unclear. SLVL, first recognized in 19791 and defined by Melo in 1987,2 then individualized by the French-American-British (FAB) group,3 is characterized by unevenly distributed cytoplasmic expansions, either thin and short or else broad based,2 in PB lymphocytes. In some papers4,5 20% to 30% of villous lymphocytes (VLs) was considered necessary to make this diagnosis, whereas in other studies,6,–8 no precise level was required, and precise morphologic description of these cells was lacking. In addition, the initial definition of VL has been extended to less distinctive features, such as cells with only irregular cytoplasmic expansions,9 and the term SLVL has then been used to encompass all or almost all SMZLs disseminating in PB.9,10 Furthermore, VLs are not specific per se, as they may be found circulating in low levels in other B-cell disorders, such as chronic lymphocytic leukemia (B-CLL) or mantle cell lymphoma (MCL)11 or even reactive conditions. However, we found that a minor subgroup of cases displaying typical and numerous basophilic VLs seems to present distinctive clinicopathologic features
To clarify the relationships between those cases and SMZLs with or without VLs, as well as with other lymphoproliferative disorders with cytoplasmic projections, such as HCL or HCL-V, we report a series of 37 cases. Cytologic and histologic specimens, as well as immunophenotype, cytogenetic features, IgVH status, and clinical characteristics, were studied to determine similarities and differences between the present series and other entities and to further delineate those cases.
Methods
Samples were collected, and clinical data were analyzed in strict accordance with the Hospices Civils de Lyon institutional review board guidelines. Informed consent was obtained in accordance with the Declaration of Helsinki.
Patient selection and clinical data
Patients were retrieved from routine and consultation cases of the hematology laboratory of the Lyon Sud University Hospital (France) displaying villous lymphocytes between 1988 and 2006. The selection of cases was based on two criteria: a particular cytologic feature characterized by numerous circulating abnormal lymphoid B cells with basophilic cytoplasm and polar villi, as assessed by microscopic analysis and a non-CLL phenotype. Those cases represent about 0.5% of all chronic lymphoid malignancies diagnosed in PB in our department, compared with 25% for classical SMZL. In all cases, PB smears obtained at diagnosis, either manually or automatically prepared by Sysmex SP-100 or SP-1000 (Roche Diagnostics, Meylan, France) and stained by May-Grünwald Giemsa, were reviewed and evaluated for cytologic features by three of the authors (P.F., D.M., and L.B.). For 12 patients, a pathologic specimen from splenectomy was available, and hematoxylin-eosin and safranin or Giemsa-stained slides were reviewed (F.B. and A.T.G.). A bone marrow (BM) biopsy at diagnosis was available and reviewed for 9 patients (M.F., A.T.G.). Clinical data at the first manifestation were obtained from the referring clinicians: age, date of diagnosis, and the extent of disease. Patients were staged following the Ann Arbor system. Performance status was evaluated according to the Eastern Cooperative Oncology Group scale. For all patients, white blood cell count with differentials, platelet counts, hemoglobin (Hb), serum lactate dehydrogenase and β2-microglobulin levels, as well as serum electrophoresis with a search for M-component, were collected. Data regarding treatment were available for 30 patients. Clinical follow-up and survival were available for 27 patients. Since those cases were not usually distinctly described in previous series of SMZL with or without VL, we compared them with a control group of 51 classical and well-defined SMZLs from our department, including previously published cases.5
Flow cytometric analysis
The fresh whole-PB and spleen cell suspensions were stained using 2, 3, or 4 combinations of monoclonal antibodies directly conjugated to fluorescein isothiocyanate (FITC), phycoerythrin (PE), PE-Texas Red (ECD), or PE-cyanin 5 (PC5). The routine monoclonal antibodies (CD classification, fluorochrome-labeled, and clone) included CD19-FITC and CD19-PE (clone HD 37), CD3-ECD (clone UCHT1), CD5-PC5 (clone BL1A), CD11c-PE (clone BU15), CD22-PE (clone 4KB128), CD23-FITC (clone MHM6), FMC7-FITC, CD25-PE (clone B1.49.9), CD27-PE (clone L128), CD38-PE (clone HB7), CD43-FITC (clone DF-T1), CD79b-PE (clone SN8), CD103-FITC (clone 2G5), and CD123-PE (clone 9F5/reagents from Beckman Coulter, Miami, FL; Becton Dickinson, San Jose, CA; or Dako, Glostrup, Denmark). Surface immunoglobulins (Igs) were analyzed using fluorescence-conjugated anti-IgG, anti-IgA, anti-IgM, anti-IgD, anti-κ, and anti-λ (Dako). Samples were analyzed on a flow cytometer (FACScan; Becton Dickinson or Coulter Epics-XL, Beckman-Coulter). A marker was considered positive when expressed on >20% of B cells above the control. Immunostaining by CD76 (Dako) was performed on cytocentrifuged preparations by the immunoalkaline phosphatase anti–alkaline phosphate technique at a 1 : 20 dilution. It was considered positive when at least 20% of atypical lymphoid cells were positive. The immunophenotype was compared to that obtained in PB or spleen in 43 cases of an SMZL control group without VL studied in the laboratory by the same techniques.
Histologic studies
For paraffin-embedded spleen and BM specimens (12 spleens and 3 BM), immunologic characterization was performed on formalin- or Bouin-fixed sections. Six BM biopsies were processed into plastic according to the methods previously described.12 Briefly, undecalcified BM specimens were fixed in phosphate-buffered saline–buffered formalin, dehydrated in acetone, and embedded in a Kushida low-viscosity glycol-methacrylate Immuno-Bed resin (Polysciences Europe, Eppelheim, Germany). Two-micrometer sections were stained by usual histologic procedures using Giemsa and eosin panoptic staining for cytologic details and Gomori silver impregnation to show reticulin fibers.
Standard immunohistochemical techniques were used on paraffin-embedded tissues, including heat-induced antigen retrieval and avidin-biotin peroxidase detection on an automated immunostainer (Benchmark; Ventana Medical System, Illkirch, France) according to the manufacturer's instructions. Appropriate positive and negative controls were run for each antibody. The immunohistochemical panel included B-cell (L26/CD20; DAKO, Carpinteria, CA; monoclonal CD79a, clone HM57; DAKO) and T-cell markers (polyclonal CD3; DAKO) and monoclonal antibodies against CD5 (clone 4C7; Novocastra Lab, Newcastle, United Kingdom), CD23 (clone 1B12; Novocastra), CD43 (clone MT1; Novocastra), CD138 (clone MI15, DAKO), MUM-1 (clone MUM-1p; DAKO), and annexin I (ANX1; BD Transduction, Le Pont de Claix, France). Expression of each of the markers was evaluated in the tumoral lymphoid cells.
On the 6 BM resin-embedded core biopsy specimens, immunohistochemistry was performed after heat-induced antigen retrieval with DAKO buffer, pH 6, antigen labeling overnight with B or T markers, tyramide amplification (Perkin Elmer, Courtaboeuf, France), and phosphatase alkaline revelation.
Cytogenetic analysis
Karyotypes were performed at diagnosis for 25 patients, as previously described13 : on PB for 19 patients, on spleen for 4 patients, and on both spleen and PB for 2 patients. Chromosomal abnormalities were described according to the international System for Human Cytogenetic Nomenclature.14 Additional fluorescent in situ hybridization (FISH) experiments were performed according to standard methods, as previously reported.15 Patients were studied for the detection of masked trisomies 3, 12, and 18, described as recurrent in SMZL. The following DNA probes were applied: a chromosome 3–specific alpha-satellite probe (D3Z1; Oncor, Gaithersburg, MD), a chromosome 12–specific alpha-satellite probe (D12Z3; Oncor), and a chromosome 18–specific alpha-satellite probe (D18Z1; Oncor). In total, 21 patients were tested for the presence of trisomy 18, 19 for the presence of trisomy 3, and 7 for the presence of trisomy 12.
IgH somatic mutation analysis
Genomic DNA was extracted from frozen cellular suspensions (28 cases) or frozen spleen specimens (5 cases) using a High Pure PCR Template Preparation Kit (Roche, Mannheim, Germany), and the concentrations were quantified by optical density at 260/280 nm. Informed consent was obtained from each patient. To avoid bias deriving from a low representation of tumoral cells in the analyzed samples and according to the morphologic and immunophenotypic analyses, we only included cases in which the fraction of malignant cells in the frozen specimen was 70% or more. The clonal rearrangement of the IgH gene was determined by polymerase chain reaction assay performed using JH and VH framework consensus primers from European BIOMED-2–concerted action.16 Framework region FR1 consensus primers and JH mix were used. The amplification products were size fractioned by 10% ethidium bromide. Direct sequencing of amplified products was performed two to four times. To allow the exclusion of Taq polymerase–induced mutations, any case showing variation in 2 sequences was submitted to sequence confirmation with at least 2 other independent polymerase chain reaction and sequencing reactions. Nucleotide sequences were aligned to corresponding germline sequences using the current databases IGMT (http://imgt.cines.fr/) and IgBLAST (http://www.ncbi.nlm.nih.gov/igblast/). Gene mutation status was determined after excluding previously published polymorphisms. Cases were considered to be mutated when they exhibited less than 98% homology with the closest germline VH genes.
Survival analyses
Overall survival was defined as the time from the date of diagnosis to the date of death or last follow-up. Time to progression (TTP) was defined as the time from date of onset of treatment to the date of the first progression or last follow-up. For patients who did not receive any specific therapy, TTP was defined as the time from the date of the decision not to treat to the date of first progression or last follow-up. Survival analyses were performed using the Kaplan-Meier method.17 The clinical evolution and survival were compared to the control group of 51 SMZLs. Differences between survival curves were evaluated using the log-rank test.
Results
Patient characteristics
The biologic and clinical characteristics of the 37 patients at the time of diagnosis are summarized in Table 1. Ten cases from the present series were included in previous clinical series of SMZLs published by our group, but as a distinct subtype called SLVL at that time.4,5 The patients included 23 men and 14 women (sex ratio, 1.64) with a median age of 77 years (range, 46–91 years). At the time of diagnosis, the white blood cell count ranged from 3.4 to 36.36 × 109/L (median, 15.8 × 109/L), and 28 patients (76%) had an elevated lymphocyte count (> 4 × 109/L; range, 4.7–33.5 × 109/L, median, 13.27). Hb values ranged from 4.9 to 15.9 g/dL, with an Hb level < 10 g/dL in 3 patients. Neutrophil counts ranged from 1.1 to 15.5 × 109/L, with neutropenia (<1.5 × 109/L) in 1 case. Platelet values ranged from 21 to 529 × 109/L, with thrombocytopenia (platelets < 100 × 109/L) for 8 patients. Monocytopenia (<0.2 × 109/L) was absent. Six cases presented a serum M component IgM or IgG or IgM + G at a low level.
Only 3 patients (13%) had a poor performance status. High lactate dehydrogenase and β2-microglobulin levels were observed in 25% and 53% of the patients, respectively. All patients presented a disseminated disease with Ann Arbor stage IV. According to the International Prognostic Index,18 21% of the patients had a low risk, 62% had low intermediate risk, and 4% had high intermediate risk.
Patients were treated according to disease stage and location with therapeutic options in use at the time of diagnosis (Table 1). Typically, elderly patients were not initially treated, except in cases of clinically aggressive disease. Patients with massive splenomegaly or marked cytopenia had a splenectomy at the time of diagnosis, either alone or followed by chlorambucil.
The clinical comparison with SMZL cases is presented in Table 1.
Cytologic features in PB
In PB, cytologic features showed a homogeneous infiltrate of small to medium-sized cells with round or oval nuclei, sometimes eccentrically placed, and dense, often clumped chromatin. The cytoplasm was variable in amount and was moderately basophilic with well-visible villous projections, unevenly distributed around the cells and with a polar distribution (Figure 1A-C). In the majority of cases, villi were broad based, whereas in others, they were rather thin. The nucleolus was small or not visible in the large majority of the cells, and was rarely prominent. Some lymphoplasmacytoid cells were often observed. A significant percentage of medium to large cells with a prominent nucleolus was present in only 4 cases, which was consistent with tumoral progression in 2 cases and transformation in the 2 others (Figure 1C). The percentage of blood infiltration by those particular VLs was always high, ranging from 26% to 91% of all lymphocytes (median, 60%).
Peripheral blood smear (May-Grünwald Giemsa staining, original magnification ×100). (A-C) Villous lymphocytes in the present series: long and large and broad-based villi unevenly distributed around the cell, round nucleus with clumped chromtin. (D,E) Cells in classical SMZL with short cytoplasmic projections (VLs). (F) Hair cells in HCL.
Peripheral blood smear (May-Grünwald Giemsa staining, original magnification ×100). (A-C) Villous lymphocytes in the present series: long and large and broad-based villi unevenly distributed around the cell, round nucleus with clumped chromtin. (D,E) Cells in classical SMZL with short cytoplasmic projections (VLs). (F) Hair cells in HCL.
Immunophenotype by flow cytometry
By flow cytometry (Table 2), there was a monoclonal B-cell population expressing surface immunoglobulin M + D (11 [31%] of 36 cases), M alone (7 [19%] of 36 cases), M + G (7 [19%] of 36 cases), or G alone (7 [19%] of 36 cases; heavy chain was absent in 3 patients and not determined in 1 case) with an equal use of kappa (18 cases) and lambda (19 cases) light chains. Cells from all cases expressed B-cell antigens (CD19, CD20). The cells expressed CD11c rather strongly in 36 (97%) of 37 cases, and CD76 in 32 (86%) of 37 cases (Table 2). CD5 and CD43 were faintly expressed in 5 (14%) of 37 and 4 (13%) of 31 cases, respectively, and only 1 case expressed CD23. CD103 was expressed with different intensities in 13 (38%) of 34 cases, and CD123 faintly in 3 (16%) of 19 cases (with a partial positivity in 1 case). The only case displaying CD25 positivity (1 [3%] of 37) also showed positivity for CD11c (moderate), CD103 (faint), and CD123 (faint).
Spleen histology and immunohistochemistry
The spleens were enlarged, weighing from 870 to 3015 g (median, 1820 g). Macroscopic analysis showed a diffuse congested pattern without a micronodular appearance. The microscopic infiltrate was monomorphic, diffuse, and predominant in the congested red pulp with sinusoidal infiltration in each case (Figure 2). In 3 cases, true blood lakes were observed, with the destruction of the cord sinus integrity and with lining of pseudosinuses by neoplastic cells (Figure 2). Those blood lakes were small in 2 of them and large in only 1 case. The white pulp was atrophic in all cases and not visible in 5 cases.
Spleen morphology on paraffin embedded tissue (hematoxylin-eosin safran stain, original magnification ×4). (A) Diffuse infiltration with disappearance of the white pulp–congested sinus. (B,C) Diffuse infiltration with predominant red pulp infiltration and residual atrophic white pulp. (D-E) Large and small blood lakes.
Spleen morphology on paraffin embedded tissue (hematoxylin-eosin safran stain, original magnification ×4). (A) Diffuse infiltration with disappearance of the white pulp–congested sinus. (B,C) Diffuse infiltration with predominant red pulp infiltration and residual atrophic white pulp. (D-E) Large and small blood lakes.
In formalin-fixed, paraffin-embedded tissue, the cytology had two distinctive features (Figure 3A,B). First, in 5 cases, the cells were small with round hyperchromatic nuclei, clumped chromatin, and basophilic cytoplasm, giving a plasmacytoid appearance. In 6 other cases, the cells were larger and presented a more irregular nucleus, having less-clumped chromatin with a less basophilic and abundant cytoplasm, except in 1 case, where the cytoplasm was clear and abundant. In 2 cases, we observed a mix of both round and irregular nuclei with more atypical cells, a prominent nucleolus in almost all nuclei, and an increase of large cells and mitoses (Figure 3C). Those cases also were considered transformed on imprints.
Spleen cytology in paraffin-embedded tissue of the present series (hematoxylin-eosin safran stain, original magnification ×100). The cells observed in the present series on spleen sections showed two distinctive features: (A) cells with round nucleus, clumped chromatin, and abundant basophilic cytoplasm, (B) cells with more irregular nucleus, less clumped chromatin, and less abundant cytoplasm, and (C) an increase in atypical cells with a prominent nucleolus, increase in large cells, and mitosis in morphologically transformed cases.
Spleen cytology in paraffin-embedded tissue of the present series (hematoxylin-eosin safran stain, original magnification ×100). The cells observed in the present series on spleen sections showed two distinctive features: (A) cells with round nucleus, clumped chromatin, and abundant basophilic cytoplasm, (B) cells with more irregular nucleus, less clumped chromatin, and less abundant cytoplasm, and (C) an increase in atypical cells with a prominent nucleolus, increase in large cells, and mitosis in morphologically transformed cases.
Immunohistochemical study of spleen sections showed a diffuse infiltrate of small B cells expressing CD20 without expression of CD5, CD23, CD43, MUM-1, and annexin I. Few mature plasma cells expressed CD138. There were few CD3+ T cells.
BM examination
A BM biopsy at diagnosis was available in 9 cases. Review of the BM infiltrates showed variable cellularity (between 15% and 80%), and a good hematopoietic reserve in normocellular or hypercellular cases. The lymphoid infiltrate between 5% and 30% was composed of atypical CD20- and CD79a-positive B cells, with an interstitial and predominantly intrasinusoidal pattern. Interestingly, the predominant intrasinusoidal pattern observed in 5 cases was associated in 4 of those cases with a PB lymphocytosis (ranging from 12.8 to 16.9 × 109/L). Staining for reticulin fibers was evaluated in each case and demonstrated at most only mild fibrosis (0–1).
Cytogenetics
Of 29 cases, 19 showed an absence of clonal chromosomal changes, either by conventional karyotype or by FISH experiments. In only 10 (34%) of 29 patients, cytogenetic abnormalities were detected. The most frequent change consisted of chromosome 7q deletion, which was identified in 4 patients. Two patients presented a complete trisomy 18, and one patient presented partial trisomy 3q (searched, respectively, in 19 and 20 patients). Among patients with clonal changes on karyotype, no t(11;14)(q13;q32) was identified. The cytogenetic abnormalities found in our SMZL control group were similar to those in previous reports.19 Briefly, analyzable metaphases were observed in 44 of the 51 cases. Clonal chromosomal changes were identified in 39 patients. Complex karyotypes with more than 3 abnormalities were found in 23 of the 39 patients with chromosomal changes. Regarding the numerical changes, most cases (72%) presented recurrent chromosomal aberrations described in SMZL: del7q in 21 patients, trisomy 3 (complete or partial +3p) in 10 patients, and trisomy 18 in 10 patients.
IgH mutational status
We amplified and sequenced 33 clonal IgVH rearrangements in 33 cases, without distinct biallelic rearrangement in any case. All cases were potentially functional without stop codons and with a JH gene in the correct reading frame. Most cases were mutated (26 [79%] of 33), with homology to the germline sequence ranging from 84.5% to 100%. The most frequent VH families used were VH4 (13 cases) and VH3 (12 cases), followed by VH1 (4 cases), VH5 (3 cases), and VH2 (1 cases). VH6 family was not represented. We identified a selective VH gene usage with overrepresentation of VH3-23 (6 cases) and VH4-34 (5 cases) gene families, whereas the VH1-2 segment, commonly found in classical SMZL, was identified in only 1 case. The IgH mutation pattern of the control SMZL group extends our previously published series of SMZLs, which did not include cases with VLs. In total, 34 cases were analyzed. Two thirds were mutated (23 of 34). The biased usage of VH1-2*04 was confirmed in 14 cases. The other cases used VH3 (14 cases, including 4 cases with VH3-23), VH4 (3 cases with VH4-34), VH2 (1 case), VH5 (1 case), and VH1-18 (1 case).
Survival and TTP
A total of 17 patients (63%) are alive, with a follow-up ranging from 3 to 190 months (median, 48 months). Figure 4 shows survival and TTP in comparison with the control group of SMZL. Compared with the SMZL control group, treatment of the present cases was more frequently watchful waiting (56% vs 24%), and fewer patients had splenectomy at the time of diagnosis (26% vs 43%). A statistical difference (P < .05) was observed in progression-free survival between the control group of SMZL and the present series (Figure 4), whereas no significant difference was observed for overall survival. The 2 cases, cytologically and histologically transformed, presented an overall survival of 50 and 69 months, respectively, with a progression-free survival of 24 and 45 months.
Progression-free survival curve of 27 patients from the present series compared with the control group of SMZL.
Progression-free survival curve of 27 patients from the present series compared with the control group of SMZL.
Discussion
Cytoplasmic expansions in PB B lymphocytes have been described in different lymphoproliferative disorders, including SMZL, HCL, and HCL-V. However, some confusion persists in the literature for the precise definition of SLVL due to the lack of consensus characterization of VL morphologic features. Indeed, variable proportions and aspects of VL in PB have been reported in SLVL, which may be considered the first description of SMZL based on PB characteristics before the true recognition of this entity by hematopathologists. Actually, SLVL is considered to be a synonym for SMZL with PB dissemination. However, we found that a minor subgroup of patients presents with numerous basophilic cells with characteristic villi, distinct from the short villoid expansions often present in a low proportion of cells in SMZL (Figure 1D,E). Those cases were included in previously published clinical series of SMZL from our group, but as a distinct group called SLVL. They present with distinctive clinicopathologic features and could account for the molecular heterogeneity of SMZL reported in the literature. To better individualize those cases, we collected 37 patients from our department and reviewed their clinical, cytologic, histologic, cytogenetic, and VH mutational patterns.
Most patients of the present series were male, advanced in age, presenting with splenomegaly and moderate lymphocytosis without pancytopenia, except for a few patients in whom hypersplenism probably accounted for some cytopenias. The cells showed particular basophilic cytoplasm with broad-based and polar villi distinct from those observed in other well-described entities. Interestingly, those particular VLs were always in a high proportion (median, 60%), forming a homogeneous infiltrate. Although only 12 spleen specimens were available, histologic features were also peculiar, with the same diffuse monomorphic infiltrate in the congested red pulp in all cases. These histologic features are not observed in well-described entities. BM core biopsies showed mild fibrosis with a good hematopoietic reserve and a mild infiltrate predominantly intrasinusoidal, in contrast with the PB lymphocytosis above the normal value observed in those cases. The monoclonal B cells expressed surface IgM + D, IgM + G, IgM, or IgG alone with an equal repartition of kappa and lambda light chains. CD11c and CD76 were strongly expressed in most cases; CD103 was present in a significant proportion of cases, whereas CD123 and CD25 were rarely observed. Although most cases showed an absence of clonal chromosomal abnormalities (66%), the most frequent change consisted of chromosome 7q deletion (4 cases), complete trisomy 18 (2 cases), and partial trisomy 3q (1 case). Most cases were mutated (79%), with a selective usage of VH3-23 and VH4-34 gene families. The clinical evolution was indolent, with transformation in 2 cases. A statistical difference (P < .05) was observed in progression-free survival with a control group of classical SMZL.
These results raise the question of the differential diagnosis of those cases with other indolent mature B-cell neoplasms presenting cytoplasmic projections in PB and splenomegaly, including SMZL with or without VL/SLVL, HCL, and HCL-V.
The comparison of the present series to a well-defined series of classical SMZL from our department shows overlapping features. Common features include the clinical presentation, except the male predominance and older age. In addition, although most karyotypes did not show chromosomal changes, in cases with clonal abnormalities, del7q and trisomy 3q, known to be recurrent in SMZL,11,20 were observed. However, the circulating cell morphology and the pattern of spleen involvement are clearly distinct (Figures 1,2). SMZL can show in few cases a diffuse pattern with expansion of the white pulp, but distinct from the red pulp infiltrate with atrophic white pulp seen in the current series. Interestingly, 4 cases of splenic lymphoma with a similar red pulp infiltration have already been published21,22 but without PB description in most cases. In fact, the diagnosis of cases similar to those in the present series is probably more often made without the availability of splenic tissue (only 26% of those patients underwent splenectomy, as opposed to 43% in classic SMZL), and the combined analysis of spleen histology and PB cytology was lacking. Del8(p11),23 reported in a case with similar red pulp infiltration but without corresponding blood smears, was not found in the present cases. The observed IgVH mutation pattern is also distinct from SMZL cases, with more cases mutated (79% vs 57%) and a different VH gene usage (predominantly VH3 and VH4), whereas the VH1-2 segment, frequently found in SMZL, was identified in only one case.24,25
Although the present series does not resemble HCL, some overlaps exist. Indeed, common features include the male predominance, the massive congested red pulp pattern, the rarity of clonal chromosomal abnormalities, and the IgH mutational pattern (most cases mutated, low degree of intraclonal heterogeneity, and similar overrepresentation of VH3-23 and VH4-3426,,,–30 ). In addition, immunophenotypic similarities include the expression of classical HCL markers (ie, CD11c, CD103, and CD123) but with a lower staining intensity than in HCL (Table 2) and a possible coexpression of preswitched (IgM/IgD) and postswitched (IgG) isotypes by the same cells (Table 2). However, patients from the present series are older (median age in HCL, 54 years31 ) without the severe pancytopenia, including monocytopenia, classically described in HCL.31 The cytoplasmic expansions are shorter and larger, with a less abundant and more basophilic cytoplasm32 and a polar distribution around the cell (Figure 1F) contrasting with the circumferential distribution observed in hairy cells. The chromatin pattern in PB and spleen is quite distinct in most cases, and the cytoplasm presents straight boundaries. The large blood lakes are inconstant and less extensive. Annexin I typically expressed in HCL33,34 is absent, such as CD25. BM displays neither massive fibrosis nor diffuse interstitial infiltration and granulocytic hypoplasia, characteristic of HCL.32
Interestingly, the overlap with HCL is reminiscent of HCL-V.35,–37 HCL-V, described by Cawley in 198035 and extensively characterized by Matutes in 2001,36 is a rare B-cell lymphoproliferative disorder with cells resembling hairy cells by showing numerous cytoplasmic projections. As in the present series, patients are older than HCL (eighth vs sixth decade), with a less important male predominance (2:1 against 5:1) and a larger splenomegaly and lymphocytosis without pancytopenia. Other similar features are cells with a more condensed chromatin and basophilic cytoplasm than in HCL, frequent expression of IgG alone or with another isotype, expression of CD11c and CD103, and absence of expression of CD25 and annexin I. The BM infiltration is also similar, with the presence of mild fibrosis, a good hematopoietic reserve, and a possible sinusoidal growth pattern.38 However, a typical finding described in HCL-V is the presence of a large nucleolus similar to prolymphocytes, which was present occasionally in the present series and prominent in only 4 cases. Another difference consists in the level of the lymphocytosis, mild to moderate in our series (median, 15.8 × 109/L), whereas it was often high in HCL-V (median, 34 × 109/L). In addition, IgG is less frequently expressed in monoclonal B cells than in HCL-V (40% vs 70%). Comparison with cytogenetic and molecular data are limited because few HCL-V cases have been published.26,36 The clinical course of HCL-V is chronic (median survival, 9 years), similar to cases from the present series. Progressive disease is rare, but transformation is possible. Another variant termed the HCL-Japanese Variant has been published with the same clinical presentation but without the nucleoli of HCL-V, as in our series, and with a higher expression of CD11c. In fact, HCL-V and HCL-Japanese Variant cases overlap strongly with the present series.
The occasional presence of prominent nucleoli in the 4 cases of the present series could also evocate prolymphocytic leukemia (PLL), another rare B-cell disease with splenomegaly and lymphocytosis. However, VLs are not described in PLL, and none of the cases of the present series had a high lymphocytosis (usually more than 100 × 109/L), as described in PLL.
The response to therapy and treatment of choice is quite different between HCL, HCL-V, and SMZL, and it is important to differentiate them. HCL is responsive to specific purine analogs; HCL-V does not respond well to purine analogs but seems to respond well to splenectomy, like SMZL. The majority of cases in the present series did not need treatment, and the TTP was significantly longer than that displayed by SMZL, including cases with transformed morphology. Only 8 patients had splenectomy, and 5 had a cytotoxic treatment at the time of diagnosis.
Indeed, the cases described herein seem to constitute a rare, distinct entity based upon the association of clinical, morphologic, immunophenotypic, cytogenetic, and molecular features. First, it underlines the interest of a precise analysis of blood films. Second, these cases display clinical and morphologic features strongly reminiscent of HCL-V, but nevertheless not quite similar. They overlap indeed with both SMZL and HCL, but they also display original features and a quite indolent clinical course (Figure 5). Then, classifying them as SMZL-V or HCL-V would be based upon subjective criteria. Therefore, we propose to consider them as a provisional entity that might be called “Splenic Red Pulp Lymphoma with Numerous Basophilic Villous Lymphocytes” in order to discriminate them from the too broadly defined SLVL and from classical SMZL and HCL. Since the cell of origin and lymphomagenesis of these disorders remain poorly characterized, further studies are necessary to explore their putative relationships (Figure 5).
Schematic representation of relationship between SMZL, HCL, HCL-V, PLL, and cases from the present series (SRPL).
Schematic representation of relationship between SMZL, HCL, HCL-V, PLL, and cases from the present series (SRPL).
The publication costs of this article were defrayed in part by page charge payment. Therefore, and solely to indicate this fact, this article is hereby marked “advertisement” in accordance with 18 USC section 1734.
Acknowledgments
This study was supported by grants from the Comité Départemental de la Ligue contre le Cancer du Rhône.
Authorship
Contribution: A.T.G. designed the research, reviewed histologic specimens, performed molecular and clinical analysis, analyzed data, and wrote the paper; L.B. performed flow cytometric analysis, reviewed cytologic specimens, and analyzed data; E.C.B. performed cytogenetic research and analyzed data; D.M. reviewed cytologic data; S.G. performed FISH and cytogenetics analysis and analyzed data; M.F. reviewed bone marrow biopsies and analyzed data; A.V. performed IgVH mutational pattern analysis; D.R. performed molecular analysis; C. T. analyzed clinical data; J.P.M. analyzed cytogenetics and FISH data; G.S. and B.C. designed the research, analyzed clinical data, and wrote the paper; F.B. designed the research, did the original description of splenic histology, reviewed histologic data, analyzed data, and wrote the paper; and P.F. designed the research, made the selection of the cases from blood smears, reviewed cytologic data, analyzed data, and wrote the paper.
Conflict-of-interest disclosure: The authors declare no competing financial interests.
Correspondence: Pascale Felman, Laboratoire d'Hématologie Biologique, Centre Hospitalier Lyon Sud, 69495 Pierre Bénite Cedex, France; e-mail: pascale.felman@chu-lyon.fr.